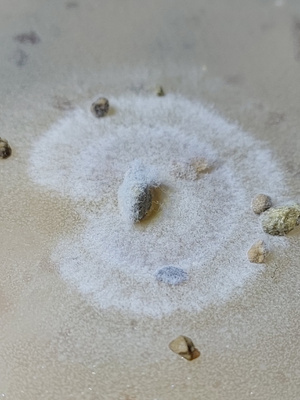

Энергия роста триходерма
Перестал шевелится малыш
Пусть не отпускает песня
Пересечение множеств 3 класс петерсон видеоурок
Резкое механическое воздействие
Деки обшивка дома
День поэзии прошло мероприятие
Влюбилась в короля школы дорама
Правовые нормы это результат развития общества аргументы
Настя и мама не песня
Как сделать пол своими руками на даче
Человек от которого плохо всем
Япония каталог сайтов
Когда тест на беременность показал результат форум
Энергия роста триходерма 155 фото